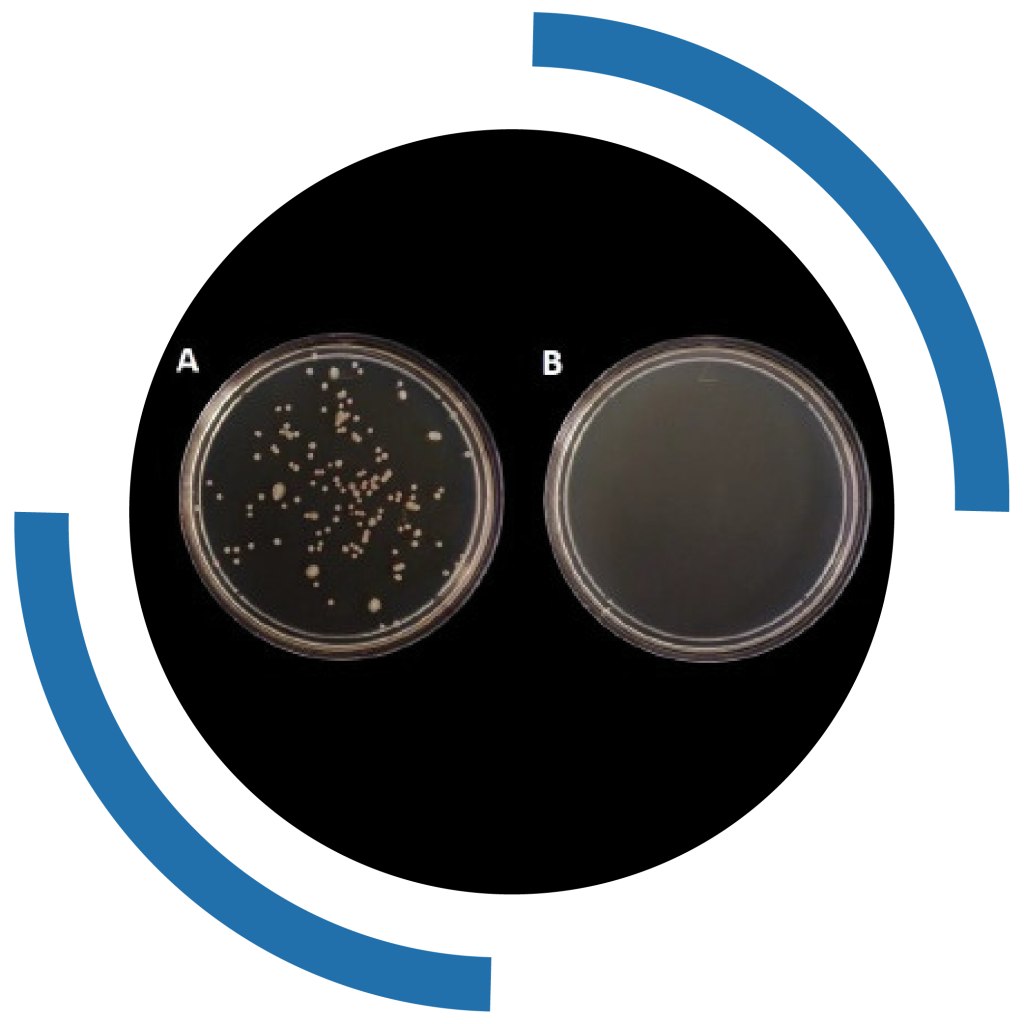

BioSystemic es un fungicida y bactericida de amplio espectro que permite una sanitización óptima de los cultivos. Sus componentes tienen un efecto de contacto y sistémico para el control de diversas enfermedades como: antracnosis, mancha café, mildiu, moho gris, entre otras. Los ingredientes activos de BioSystemic tienen una acción translaminar, ya que son absorbidos dentro de la cutícula de las plantas, lo cual garantiza su efectividad contra los distintos fitopatógenos. Su actividad fungicida se basa en la inhibición de la germinación de esporas y del crecimiento micelial, mientras que en bacterias impide su crecimiento y provoca su muerte atrofiando sus paredes celulares. De igual modo las biomoléculas que lo componen activan el sistema de resistencia adquirida (SAR) e induce la producción endógena de enzimas de resistencia al estrés y de hormonas de crecimiento.



BioSystemic Nanobacter es un bactericida de amplio espectro que gracias a su composición de biomoléculas nanoemulsionadas permite su absorción a través de la membrana celular de las bacterias para su liberación dentro de ellas, provocando alteraciones irreparables en dichos microorganismos. De igual modo las biomoléculas que lo componen activan el sistema de resistencia adquirida (SAR) e induce la producción endógena de enzimas de resistencia al estrés y de hormonas de crecimiento.

BioSystemic HI-BLOQ es un insecticida que gracias a su composición de biomoléculas nanoemulsionadas permite la penetración de metabolitos activos en estructuras blandas, provocando en los insectos quemaduras, asfixia, bloqueo de receptores, toxicidad y repelencia; brindando con estos mecanismos de acción los efectos: ovicida, ninficida y acaricida.


ALZOR Biotechnologies® forma parte de una nueva revolución tecnológica para la agricultura mundial, mediante el aprovechamiento de biomoléculas y nanomateriales para el desarrollo de agroinsumos biotecnológicos de alta efectividad y bajo impacto ambiental.
© Copyright COTOWEB 2025. All rights reserved.

